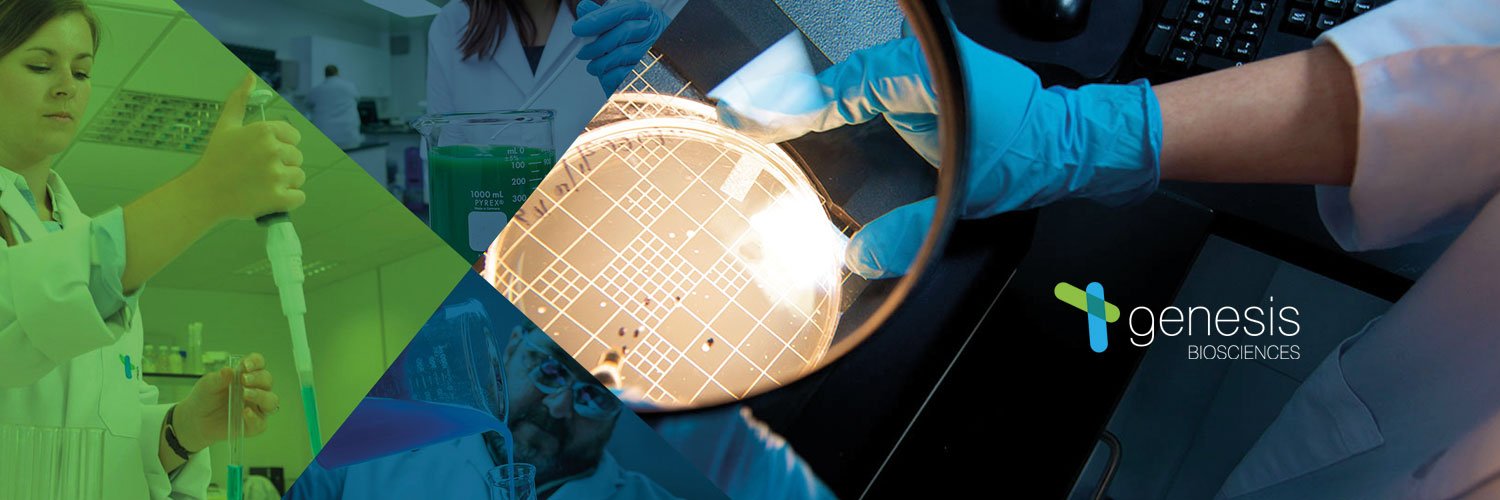
Genesis Biosciences banner

Myth: Green products don't work effectively.
Fact: Our eco-benign® chemistry is designed to enhance microbial performance, not limit it! Delivering effective results with lower environmental impact.
Discover solutions that work tinyurl.com/5ded8nye

English